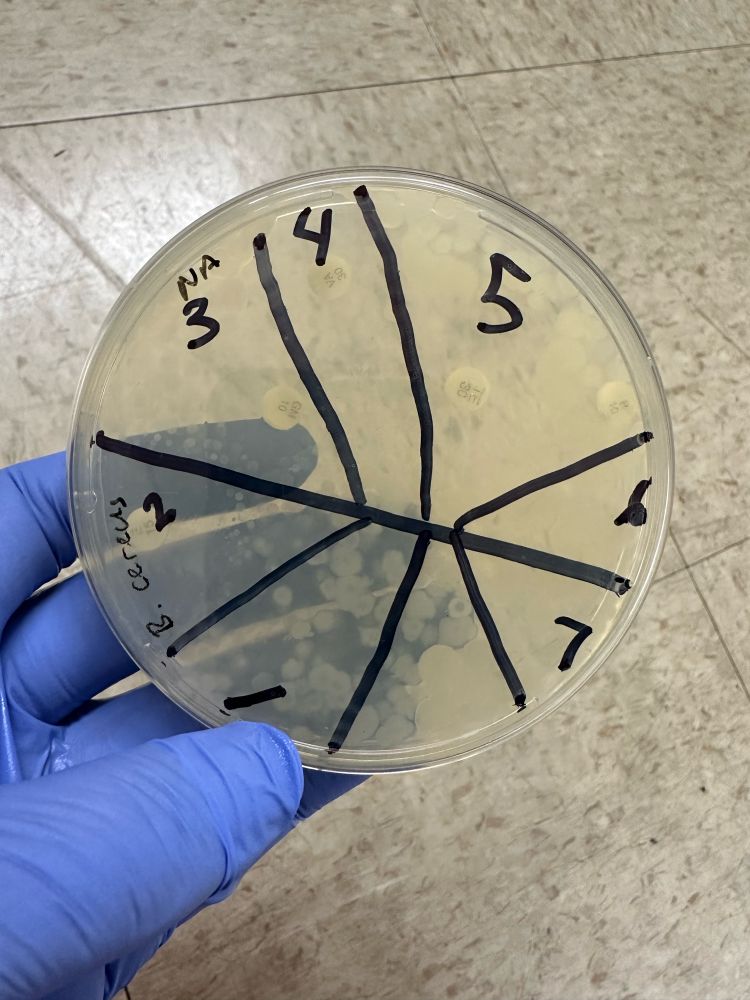
A bacterial plate held by a gloved hand. The sharpie lines should be drawn to evenly split the circle into 6 pieces, but instead the student has drawn an insect-like line and divided the circular tray into 7 different sections, each one a different shape and size. On the plate ager are antibiotic tabs and some bacterial growth.

"Advertisement for a non-science major general biology course". 🧪
The least bad of the botched CAPTCHA dumpster fires I received:

"Advertisement for a non-science major general biology course". 🧪
The least bad of the botched CAPTCHA dumpster fires I received:
Putting my lab magnifying glasses to good use this Halloween 🧪


Putting my lab magnifying glasses to good use this Halloween 🧪
Etsy has curated a collection for me called "frog for her"

Etsy has curated a collection for me called "frog for her"






